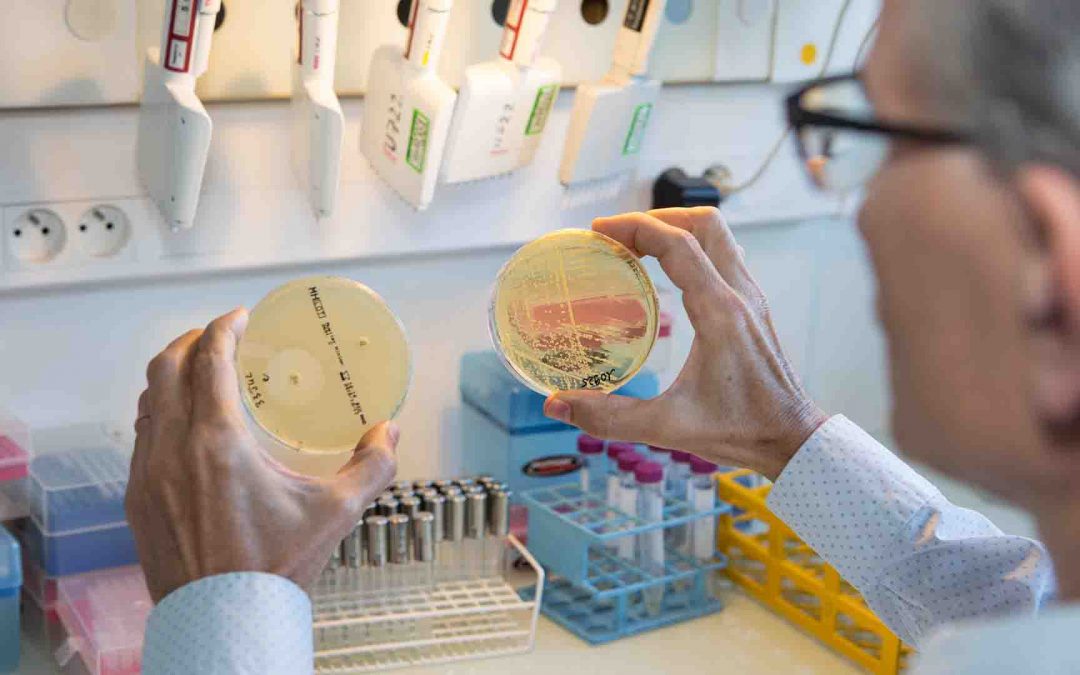
FHU : Université Paris Cité remporte plus de la moitié des projets labellisés

1 avril 2020 | Covid-19, Faculté de Santé, Faculté des Sciences, Université Paris Cité
Les UFR de Médecine et d’Odontologie, l’IUT de Paris – Pajol, le FabLab d’Université Paris Cité, le PARCC Inserm et Centrale-Supélec conjuguent leurs forces, dans le cadre du projet collectif 3D4Care, pour créer des visières de protection et...

27 février 2020 | Accueil, Faculté de Santé, Recherche
Les régimes amaigrissants font sans cesse la une de la presse grand public, en particulier des magazines de santé / bien-être. Les retours d’expérience révèlent souvent une inefficacité ou une efficacité transitoire ! Que dit la science de ces régimes ?...

15 janvier 2020 | Accueil, Faculté de Santé, Presse, Recherche
Les résultats de l’appel à projets Fédérations hospitalo-universitaires viennent d’être communiqués. Découvrez les lauréats. Chaque FHU est constituée sur un thème médical défini, au sein des périmètres hospitalo-universitaires (dont au moins une...

9 janvier 2020 | Campus, Faculté de Santé, Formation
Une nouvelle bibliothèque vient s’ajouter aux 21 bibliothèques que compte Université Paris Cité : la BU Necker. Moderne et lumineuse, cette nouvelle bibliothèque universitaire est dotée de 260 places, de 10 salles de travail en petit groupe, d’une salle de...

4 décembre 2019 | Faculté de Santé, Faculté des Sciences, Faculté Sociétés et Humanités, Formation
À l’approche des examens, le Docteur Boris Hansel vous parle de cerveau et de mémoire dans PuMS, l’émission de santé. Découvrez les conseils d’expert.e.s qui vous permettront de mieux mémoriser vos cours ! Comment stimuler son cerveau et le garder en pleine santé ? Le...